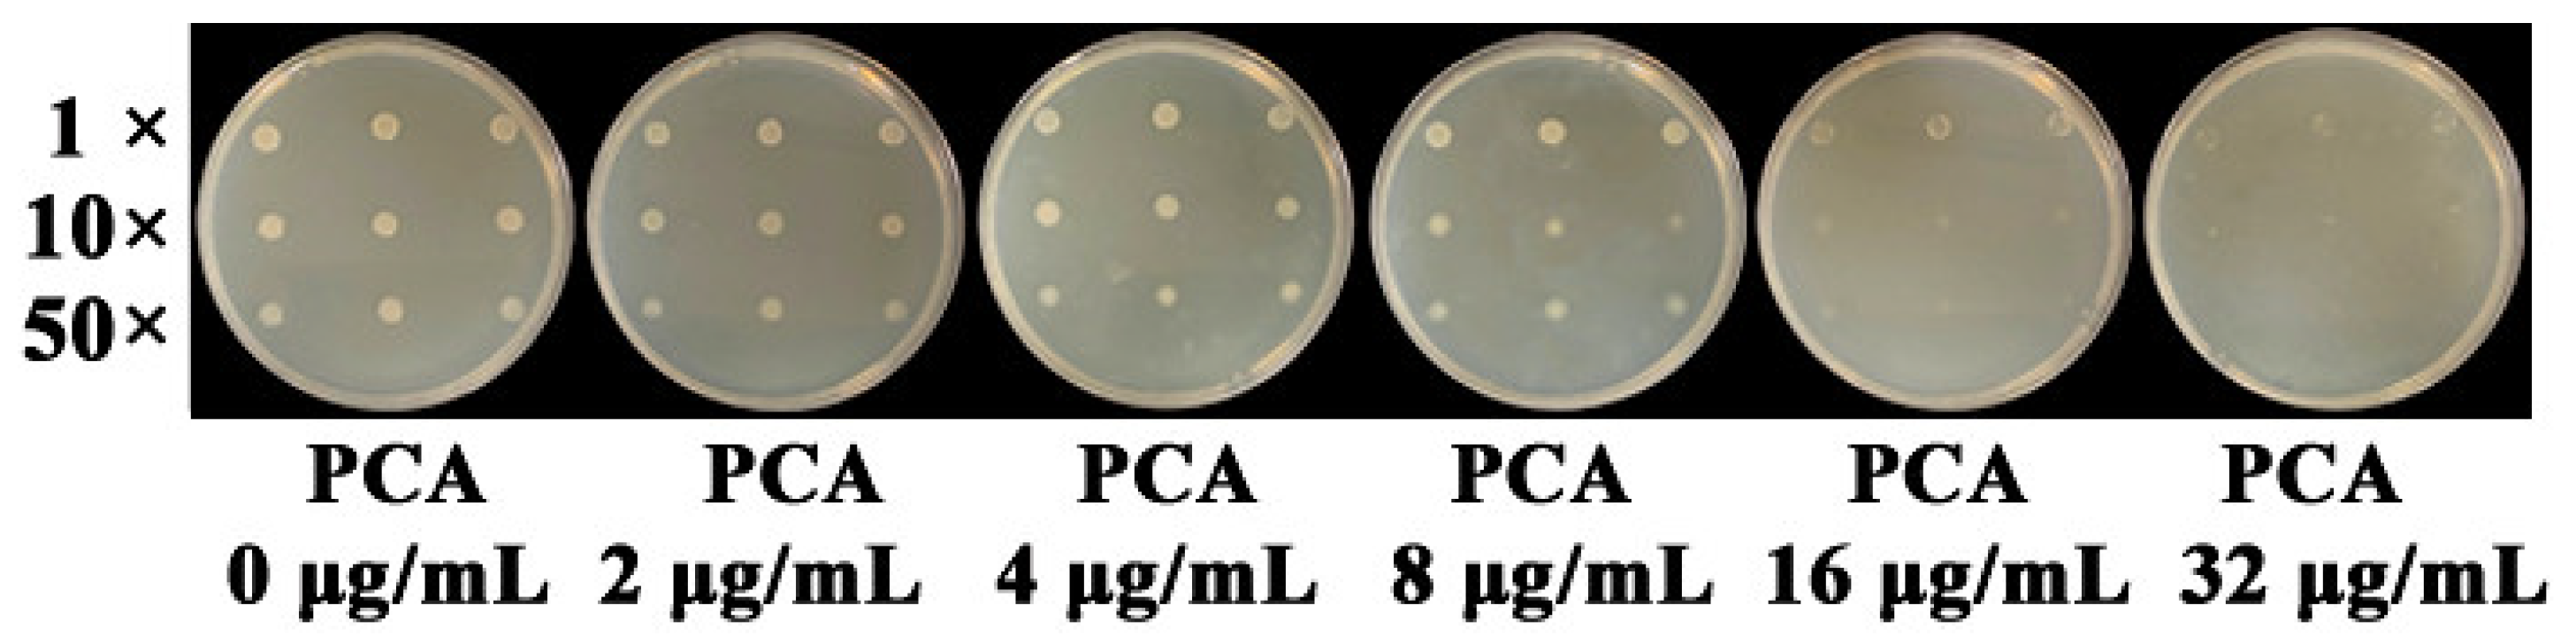
Microorganisms 09 02012 g004

Phenazine-1-carboxylic Acid Produced by Pseudomonas chlororaphis YL-1 Is Effective against Acidovorax citrulli
Abstract
:1. Introduction
2. Materials and Methods
2.1. Microorganisms, Media, and Culture Conditions
2.2. Generation of Deletion Mutants
2.3. Growth, Hydrogen Cyanide and Pyoverdine Measurements
2.4. Antibacterial Activity of Strain YL-1 and Mutants
2.5. Extraction and Determination of PCA
2.6. Inhibition of PCA against A. citrulli
2.7. Transcript Levels of Transcriptional Regulator Genes as Affected by PCA
2.8. ROS Accumulation, Activities of Superoxide Dismutase (SOD) and CAT in A. citrulli Induced by PCA
2.9. Sensitivity of A. citrulli as Affected by Exogenous H2O2
2.10. Inhibition of PCA against A. citrulli as Affected by Exogenous CAT
2.11. Statistical Analysis
3. Results
3.1. Growth, Hydrogen Cyanide and Pyoverdine Production of P. chlororaphis YL-1 and Mutants
3.2. Antibacterial Activity of P. chlororaphis YL-1 and Mutants
3.3. Isolation and Purification of Phenazine
3.4. The Inhibition of PCA against A. citrulli
3.5. Expression of oxyR, soxR, and the Genes Involved in Antioxidant Systems as Affected by PCA
3.6. ROS Accumulation, CAT and SOD Activities Induced by PCA
3.7. Sensitivity of A. citrulli as Affected by Exogenous H2O2
3.8. Inhibition of PCA against A. citrulli as Affected by Exogenous CAT
4. Discussion
Supplementary Materials
Author Contributions
Funding
Institutional Review Board Statement
Informed Consent Statement
Data Availability Statement
Acknowledgments
Conflicts of Interest
References
- Conceicão, C.S.; Felix, K.C.S.; Mariano, R.L.R.; Medeiros, E.V.; Souza, E.B. Combined effect of yeast and silicon on the control of bacterial fruit blotch in melon. Sci. Hortic. 2014, 174, 164–170. [Google Scholar] [CrossRef]
- Somodi, G.C.; Jones, J.B.; Hopkins, D.L.; Stall, R.E.; Kucharek, T.A.; Hodge, N.C.; Watterson, J.C. Occurrence of a bacterial fruit blotch in Florida. Plant Dis. 1991, 75, 1053–1056. [Google Scholar] [CrossRef]
- Dutta, B.; Scherm, H.; Gitaitis, R.D.; Walcott, R.R. Acidovorax citrulli seed inoculum load affects seedling transmission and spread of bacterial fruit blotch of watermelon under greenhouse conditions. Plant Dis. 2012, 96, 705–711. [Google Scholar] [CrossRef] [PubMed]
- Latin, R.; Hopkins, D.L. Bacterial fruit blotch of watermelon: The hypothetical exam question becomes reality. Plant Dis. 1995, 79, 761–765. [Google Scholar] [CrossRef]
- Lessl, J.T.; Fessehaie, A.; Walcott, R.R. Colonization of female watermelon blossoms by Acidovorax avenae ssp. citrulli and the relationship between blossom inoculum dosage and seed infestation. J. Phytopathol. 2007, 155, 114–121. [Google Scholar] [CrossRef]
- Walcott, R.R.; Gitaitis, R.D.; Castro, A.C. Role of blossoms in watermelon seed infestation by Acidovorax avenae subsp. citrulli. Phytopathology 2003, 93, 528–534. [Google Scholar] [CrossRef] [Green Version]
- Kubota, M.; Hagiwara, N.; Shirakawa, T. Disinfection of seeds of cucurbit crops infested with Acidovorax citrulli with dry heat treatment. J. Phytopathol. 2012, 160, 364–368. [Google Scholar] [CrossRef]
- Lu, Y.; Deblais, L.; Rajashekara, G.; Miller, S.A.; Helmy, Y.A.; Zhang, H.J.; Wu, P.; Qiu, Y.H.; Xu, X.L. High-throughput screening reveals small molecule modulators inhibitory to Acidovorax citrulli. Plant Pathol. 2020, 69, 818–826. [Google Scholar] [CrossRef]
- Zhao, T.C.; Sun, F.Z.; Wang, J.R.; Xie, Y.J. Control of bacterial fruit blotch of hami melon by seed treatment with bactericides. Plant Prot. 2003, 29, 50–52, (In Chinese with an English Abstract). [Google Scholar]
- Lee, S.; Kim, H.; Beuchat, L.R.; Ryu, J.H. Development of a decontamination method to inactivate Acidovorax citrulli on Cucurbitaceae seeds without loss of seed viability. J. Sci. Food Agric. 2019, 99, 5734–5739. [Google Scholar] [CrossRef]
- Fravel, D.R. Commercialization and implementation of biocontrol. Ann. Rev. Phytopathol. 2005, 43, 337–359. [Google Scholar] [CrossRef] [PubMed]
- Rahimi-Midani, A.; Kim, J.O.; Kim, J.H.; Lim, J.; Kim, M.K.; Choi, T.J. Potential use of newly isolated bacteriophage as a biocontrol against Acidovorax citrull. Arch. Microbiol. 2019, 202, 377–389. [Google Scholar] [CrossRef] [PubMed]
- Johnson, K.L.; Minsavage, G.V.; Le, T.; Jones, J.B.; Walcott, R.R. Efficacy of a nonpathogenic Acidovorax citrulli strain as a biocontrol seed treatment for bacterial fruit blotch of cucurbits. Plant Dis. 2011, 95, 697–704. [Google Scholar] [CrossRef] [Green Version]
- Jiang, C.H.; Wu, F.; Yu, Z.Y.; Xie, P.; Ke, H.J.; Li, H.W.; Yu, Y.Y.; Guo, J.H. Study on screening and antagonistic mechanisms of Bacillus amyloliquefaciens 54 against bacterial fruit blotch (BFB) caused by Acidovorax avenae subsp. citrulli. Microbiol. Res. 2015, 170, 95–104. [Google Scholar] [CrossRef] [PubMed]
- Wu, L.Y.; Liu, B.Y.; Wang, Y.J.; Liu, S.P.; Zhao, T.C.; Hu, J. Isolation and identification of bio-control bacterial strain BW-6 against bacterial fruit blotch of sweet melon. Plant Prot. 2014, 40, 43–47, (In Chinese with an English abstract). [Google Scholar]
- Medeiros, F.H.V.; Moraes, I.S.F.; Silva-Neto, E.B.; Silveira, E.B.; Mariano, R.L.R. Management of melon bacterial blotch by plant beneficial bacteria. Phytoparasitica 2009, 37, 453–460. [Google Scholar] [CrossRef]
- Fessehaie, A.; Walcott, R.R. Biological control to protect watermelon blossoms and seed from infection by Acidovorax avenae subsp. citrulli. Phytopathology 2005, 95, 413–419. [Google Scholar] [CrossRef] [Green Version]
- Wang, X.D.; Li, G.Q.; Jiang, D.H.; Huang, H.C. Screening of plant epiphytic yeasts for biocontrol of bacterial fruit blotch (Acidovorax avenae subsp. citrulli) of hami melon. Biol. Control 2009, 50, 164–171. [Google Scholar] [CrossRef]
- Melo, E.A.; Mariano, R.L.R.; Laranjeira, D.; Santos, L.A.; Gusmão, L.O.; Souza, E.B. Efficacy of yeast in the biocontrol of bacterial fruit blotch in melon plants. Trop. Plant. Pathol. 2015, 40, 56–64. [Google Scholar] [CrossRef]
- Gao, T.Y.; Hao, F.M.; Yang, D.; Bie, Z.L.; Li, G.Q. Oxalic acid produced by Aspergillus niger Y-1 is effective for suppression of bacterial fruit blotch of watermelon seedlings. Biol. Control 2017, 112, 28–33. [Google Scholar] [CrossRef]
- Ramamoorthy, V.; Viswanathan, R.; Raguchander, T.; Prakasam, V.; Samiyappan, R. Induction of systemic resistance by plant growth promoting rhizobacteria in crop plants against pests and diseases. Crop Prot. 2001, 20, 1–11. [Google Scholar] [CrossRef]
- Liu, Y.Z.; Lu, S.E.; Baird, S.M.; Qiao, J.Q.; Du, Y. Draft genome sequence of Pseudomonas chlororaphis YL-1, a biocontrol strain suppressing plant microbial pathogens. Genome Announc. 2014, 2, e01225-13. [Google Scholar] [CrossRef] [PubMed] [Green Version]
- Liu, Y.Z.; Lu, S.E.; Baird, S.M.; Qiao, J.Q.; Du, Y. Cloning the genes of Pseudomonas chlororaphis YL-1 dedicated to antibacterial activities against microbial phytopathogens. Acta Phytopathol. Sin. 2015, 45, 307–316. [Google Scholar]
- Mossialos, D.; Amoutzias, G.D. Siderophores in fluorescent pseudomonads: New tricks from an old dog. Future Microbiol. 2007, 2, 387–395. [Google Scholar] [CrossRef]
- Liu, Y.Z.; Dai, C.; Zhou, Y.Q.; Qiao, J.Q.; Tang, B.; Yu, W.J.; Zhang, R.S.; Liu, Y.F.; Lu, S.E. Pyoverdines are essential for the antibacterial activity of Pseudomonas chlororaphis YL-1 under low-iron conditions. Appl. Environ. Microbiol. 2021, 87, e02840-20. [Google Scholar] [CrossRef]
- Owen, J.G.; Ackerley, D.F. Characterization of pyoverdine and achromobactin in Pseudomonas syringae pv. phaseolicola 1448a. BMC Microbiol. 2011, 11, 218. [Google Scholar] [CrossRef] [Green Version]
- Pawar, S.; Chaudhari, A.; Prabha, R.; Shukla, R.; Singh, D.P. Microbial pyrrolnitrin: Natural metabolite with immense practical utility. Biomolecules 2019, 9, 443. [Google Scholar] [CrossRef] [Green Version]
- Michelsen, C.F.; Stougaard, P. Hydrogen cyanide synthesis and antifungal activity of the biocontrol strain Pseudomonas fluorescens In5 from Greenland is highly dependent on growth medium. Can. J. Microbiol. 2012, 58, 381–390. [Google Scholar] [CrossRef]
- Mavrodi, D.V.; Blankenfeldt, W.; Thomashow, L.S. Phenazine compounds in fluorescent Pseudomonas spp. biosynthesis and regulation. Ann. Rev. Phytopathol. 2006, 44, 417–445. [Google Scholar] [CrossRef]
- Biessy, A.; Filion, M. Phenazines in plant-beneficial Pseudomonas spp.: Biosynthesis, regulation, function and genomics. Environ. Microbiol. 2018, 20, 3905–3917. [Google Scholar] [CrossRef] [Green Version]
- Letourneau, M.; Marshall, M.J.; Cliff, J.; Bonsall, R.F.; Dohnalkova, A.C.; Mavrodi, D.; Devi, S.I.; Mavrodi, O.; Harsh, J.B.; Weller, D.M.; et al. Phenazine-1-carboxylic acid and soil moisture influence biofilm development and turnover of rhizobacterial biomass on wheat root surfaces. Environ. Microbiol. 2018, 20, 2178–2194. [Google Scholar] [CrossRef] [PubMed]
- Maddula, V.K.; Zhang, Z.; Pierson, E.; Pierson, L. Quorum sensing and phenazines are involved in biofilm formation by Pseudomonas chlororaphis (aureofaciens) strain 30–84. Microb. Ecol. 2006, 52, 289–301. [Google Scholar] [CrossRef] [PubMed] [Green Version]
- King, E.O.; Ward, M.K.; Raney, D.E. Two simple media for the demonstration of pyocyanin and fluorescein. J. Clin. Lab. Med. 1954, 44, 301–307. [Google Scholar]
- Zhu, X.; van Pée, K.; Naismith, J.H. The ternary complex of PrnB (the second enzyme in the pyrrolnitrin biosynthesis pathway), tryptophan, and cyanide yields new mechanistic insights into the indolamine dioxygenase superfamily. J. Biol. Chem. 2010, 285, 21126–21133. [Google Scholar] [CrossRef] [PubMed] [Green Version]
- Laville, J.; Blumer, C.; Schroetter, C.V.; Gaia, V.; Defago, G.; Keel, C.; Haas, D. Characterization of the hcnABC gene cluster encoding hydrogen cyanide synthase and anaerobic regulation by ANR in the strictly aerobic biocontrol agent Pseudomonas fluorescens CHA0. J. Bacteriol. 1998, 180, 3187–3196. [Google Scholar] [CrossRef] [Green Version]
- Mossialos, D.; Ochsner, U.; Baysse, C.; Chablain, P.; Pirnay, J.; Koedam, N.; Budzikiewicz, H.; Fernández, D.U.; Schäfer, M.; Ravel, J.; et al. Identification of new, conserved, non-ribosomal peptide synthetases from fluorescent pseudomonads involved in the biosynthesis of the siderophore pyoverdine. Mol. Microbiol. 2002, 45, 1673–1685. [Google Scholar] [CrossRef] [Green Version]
- Berti, A.D.; Thomas, M.G. Analysis of achromobactin biosynthesis by Pseudomonas syringae pv. syringae B728a. J. Bacteriol. 2009, 191, 4594–4604. [Google Scholar] [CrossRef] [Green Version]
- Gay, P.; Coq, D.L.; Steinmetz, M.; Ferrari, E.; Hoch, J.A. Cloning structural gene sacB, which codes for exoenzyme levansucrase of Bacillus subtilis: Expression of the gene in Escherichia coli. J. Bacteriol. 1983, 153, 1424–1431. [Google Scholar] [CrossRef] [Green Version]
- Hoang, T.T.; Karkhoff-Schweizer, R.R.; Kutchma, A.J.; Schweizer, H.P. A Broad-Host-Range Flp-FRT Recombination System for Site-Specific Excision of Chromosomally-Located DNA Sequences: Application for Isolation of Unmarked Pseudomonas aeruginosa Mutants. Gene 1998, 212, 77–86. [Google Scholar] [CrossRef]
- Simon, R.; Priefer, U.; Piihler, A. A broad host range mobilization system for in vivo genetic engineering: Transposon mutagenesis in Gram-negative bacteria. Nat. Biotechnol. 1983, 1, 784–791. [Google Scholar] [CrossRef]
- Liu, Y.Z.; Zhang, T.T.; Zhou, Y.Q.; Qiao, J.Q.; Liu, Y.F. Establishment of sacB-mediated genetic manipulation system of Pseudomonas chlororaphis YL-1. Chin. J. Biol. Control. 2019, 35, 622–629. [Google Scholar]
- Bharucha, U.D.; Patel, K.C.; Trivedi, U.B. Antifungal activity of catecholate type siderophore produced by Bacillus sp. Int. J. Res. Pharm. Sci. 2013, 4, 528–531. [Google Scholar]
- Lorck, H. Production of hydrocyanic acid by bacteria. Physiol. Plant 1948, 1, 142–146. [Google Scholar] [CrossRef]
- Ge, Y.H.; Huang, X.Q.; Wang, S.L.; Zhang, X.H.; Xu, Y.Q. Phenazine-1-carboxylic acid is negatively regulated and pyoluteorin positively regulated by gacA in Pseudomonas sp. M18. FEMS Microbiol. Lett. 2004, 237, 41–47. [Google Scholar] [CrossRef] [PubMed]
- Pan, X.Y.; Xu, S.; Wu, J.; Luo, J.Y.; Duan, Y.B.; Wang, J.X.; Zhang, F. Screening and characterization of Xanthomonas oryzae pv. oryzae strains with resistance to pheazine-1-carboxylic acid. Pestic. Biochem. Physiol. 2018, 145, 8–14. [Google Scholar] [CrossRef] [PubMed]
- Pan, X.Y.; Wu, J.; Xu, S.; Duan, T.T.; Duan, Y.B.; Wang, J.X.; Zhang, F.; Zhou, M.G. Contribution of OxyR towards differential sensitivity to antioxidants in Xanthomonas oryzae pathovars oryzae and oryzicola. Mol. Plant-Microbe Interact. 2018, 31, 1244–1256. [Google Scholar] [CrossRef] [Green Version]
- Liu, J.; Tian, Y.L.; Zhao, Y.Q.; Zeng, R.; Chen, B.H.; Hu, B.S. Ferric uptake regulator (FurA) is required for Acidovorax citrulli virulence on watermelon. Phytopathology 2019, 109, 1997–2008. [Google Scholar] [CrossRef]
- West, S.E.H.; Schweizer, H.P.; Dall, C.; Sample, A.K.; Runyen-Janecky, L.J. Construction of improved Escherichia-Pseudomonas shuttle vectors derived from pUC18/19 and sequence of the region required for their replication in Pseudomonas aeruginosa. Gene 1994, 148, 81–86. [Google Scholar] [CrossRef]
- Mavrodi, D.V.; Ksenzenko, V.N.; Bonsall, R.F.; Cook, R.J.; Boronin, A.M.; Thomashow, L.S. A seven-gene locus for synthesis of phenazine-1-carboxylic acid by Pseudomonas fluorescens 2–79. J. Bacteriol. 1998, 180, 2541–2548. [Google Scholar] [CrossRef] [Green Version]
- Chin-A-Woeng, T.F.; van den Broek, D.; Lugtenberg, B.J.; Bloemberg, G.V. The Pseudomonas chlororaphis PCL1391 sigma regulator psrA represses the production of the antifungal metabolite phenazine-1-carboxamide. Mol. Plant-Microbe Interact. 2005, 18, 244–253. [Google Scholar] [CrossRef]
- Recinos, D.A.; Sekedat, M.D.; Hernandez, A.; Cohen, T.S.; Sakhtah, H.; Prince, A.S.; Price-Whelan, A.; Dietrich, L.E. Redundant phenazine operons in Pseudomonas aeruginosa exhibit environment-dependent expression and differential roles in pathogenicity. Proc. Natl. Acad. Sci. USA 2012, 109, 19420–19425. [Google Scholar] [CrossRef] [PubMed] [Green Version]
- Liu, Y.; Baird, S.M.; Qiao, J.; Du, Y.; Lu, S.E. SecG is required for antibiotic activities of Pseudomonas sp. YL23 against Erwinia amylovora and Dickeya chrysanthemi. J. Basic Microbiol. 2015, 55, 617–624. [Google Scholar] [CrossRef] [PubMed]
- Nikolaidis, M.; Mossialos, D.; Oliver, S.G.; Amoutzias, G.D. Comparative analysis of the core proteomes among the Pseudomonas major evolutionary groups reveals species-specific adaptations for Pseudomonas aeruginosa and Pseudomonas chlororaphis. Diversity 2020, 12, 289. [Google Scholar] [CrossRef]
- Park, J.Y.; Oh, S.A.; Anderson, A.J.; Neiswender, J.; Kim, J.C.; Kim, Y.C. Production of the antifungal compounds phenazine and pyrrolnitrin from Pseudomonas chlororaphis O6 is differentially regulated by glucose. Lett. Appl. Microbiol. 2011, 52, 532–537. [Google Scholar] [CrossRef] [PubMed]
- Pan, X.Y.; Wu, J.; Xu, S.; Duan, Y.B.; Zhou, M.G. CatB is critical for total catalase activity and reduces bactericidal effects of phenazine-1-carboxylic acid on Xanthomonas oryzae pv. oryzae and X. oryzae pv. oryzicola. Phytopathology 2017, 107, 163–172. [Google Scholar] [CrossRef] [PubMed] [Green Version]
- Han, F.; Yan, R.; Zhang, M.; Xiang, Z.; Wu, Q.L.; Li, J.K. Synthesis and bioactivities of phenazine-1-carboxylic piperazine derivatives. Nat. Prod. Res. 2020, 34, 1282–1287. [Google Scholar] [CrossRef]
- Zhang, L.; Tian, X.; Kuang, S.; Liu, G.; Zhang, C.; Sun, C. Antagonistic activity and mode of action of phenazine-1-carboxylic acid, produced by marine bacterium Pseudomonas aeruginosa PA31x, against Vibrio anguillarum in vitro and in a zebrafish in vivo model. Front. Microbiol. 2017, 8, 289. [Google Scholar] [CrossRef] [Green Version]
- Arseneault, T.; Roquigny, R.; Novinscak, A.; Goyer, C.; Filion, M. Phenazine-1-carboxylic acid-producing Pseudomonas synxantha LBUM223 alters the transcriptome of Streptomyces scabies, the causal agent of potato common scab. Physiol. Mol. Plant. Pathol. 2020, 110, e101480. [Google Scholar] [CrossRef]
- Zhao, Y.; Nickels, L.M.; Wang, H.; Ling, J.; Zhong, Z.T.; Zhu, J. OxyR-regulated catalase activity is critical for oxidative stress resistance, nodulation and nitrogen fixation in Azorhizobium caulinodans. FEMS Microbiol. Lett. 2016, 363, efnw130. [Google Scholar] [CrossRef] [Green Version]
- Ochsner, U.A.; Vasil, M.L.; Alsabbagh, E.; Parvatiyar, K.; Hassett, D.J. Role of the Pseudomonas aeruginosa oxyR-recG operon in oxidative stress defense and DNA repair: OxyR-dependent regulation of katB-ankB, ahpB, and ahpC-ahpF. J. Bacteriol. 2000, 182, 4533–4544. [Google Scholar] [CrossRef] [Green Version]
- Fernandez, N.L.; Waters, C.M. Cyclic di-GMP increases catalase production and hydrogen peroxide tolerance in Vibrio cholerae. Appl. Environ. Microbiol. 2019, 85, e1043-19. [Google Scholar] [CrossRef] [Green Version]
- Tondo, M.L.; Petrocelli, S.; Ottado, J.; Orellano, E.G. The monofunctional catalase KatE of Xanthomonas axonopodis pv. citri is required for full virulence in citrus plants. PLoS ONE 2010, 5, e10803. [Google Scholar] [CrossRef] [PubMed] [Green Version]
- Lee, H.; Yoon, J.H.; Nam, J.S.; Kim, Y.M.; Ro, Y.T. Cloning, expression and characterization of the catalase-peroxidase (KatG) gene from a fast-growing Mycobacterium sp. strain JC1 DSM 3803. J. Biochem. 2010, 147, 511–522. [Google Scholar] [CrossRef] [PubMed]
- Najmuldeen, H.; Alghamdi, R.; Alghofaili, F.; Yesilkaya, H. Functional assessment of microbial superoxide dismutase isozymes suggests a differential role for each isozyme. Free Radic. Biol. Med. 2019, 134, 215–228. [Google Scholar] [CrossRef] [PubMed]

Publisher’s Note: MDPI stays neutral with regard to jurisdictional claims in published maps and institutional affiliations. |
© 2021 by the authors. Licensee MDPI, Basel, Switzerland. This article is an open access article distributed under the terms and conditions of the Creative Commons Attribution (CC BY) license (https://creativecommons.org/licenses/by/4.0/).
Share and Cite
Liu, Y.; Zhou, Y.; Qiao, J.; Yu, W.; Pan, X.; Zhang, T.; Liu, Y.; Lu, S.-E. Phenazine-1-carboxylic Acid Produced by Pseudomonas chlororaphis YL-1 Is Effective against Acidovorax citrulli. Microorganisms 2021, 9, 2012. https://doi.org/10.3390/microorganisms9102012
Liu Y, Zhou Y, Qiao J, Yu W, Pan X, Zhang T, Liu Y, Lu S-E. Phenazine-1-carboxylic Acid Produced by Pseudomonas chlororaphis YL-1 Is Effective against Acidovorax citrulli. Microorganisms. 2021; 9(10):2012. https://doi.org/10.3390/microorganisms9102012
Chicago/Turabian StyleLiu, Youzhou, Yaqiu Zhou, Junqing Qiao, Wenjie Yu, Xiayan Pan, Tingting Zhang, Yongfeng Liu, and Shi-En Lu. 2021. "Phenazine-1-carboxylic Acid Produced by Pseudomonas chlororaphis YL-1 Is Effective against Acidovorax citrulli" Microorganisms 9, no. 10: 2012. https://doi.org/10.3390/microorganisms9102012
APA StyleLiu, Y., Zhou, Y., Qiao, J., Yu, W., Pan, X., Zhang, T., Liu, Y., & Lu, S.-E. (2021). Phenazine-1-carboxylic Acid Produced by Pseudomonas chlororaphis YL-1 Is Effective against Acidovorax citrulli. Microorganisms, 9(10), 2012. https://doi.org/10.3390/microorganisms9102012




